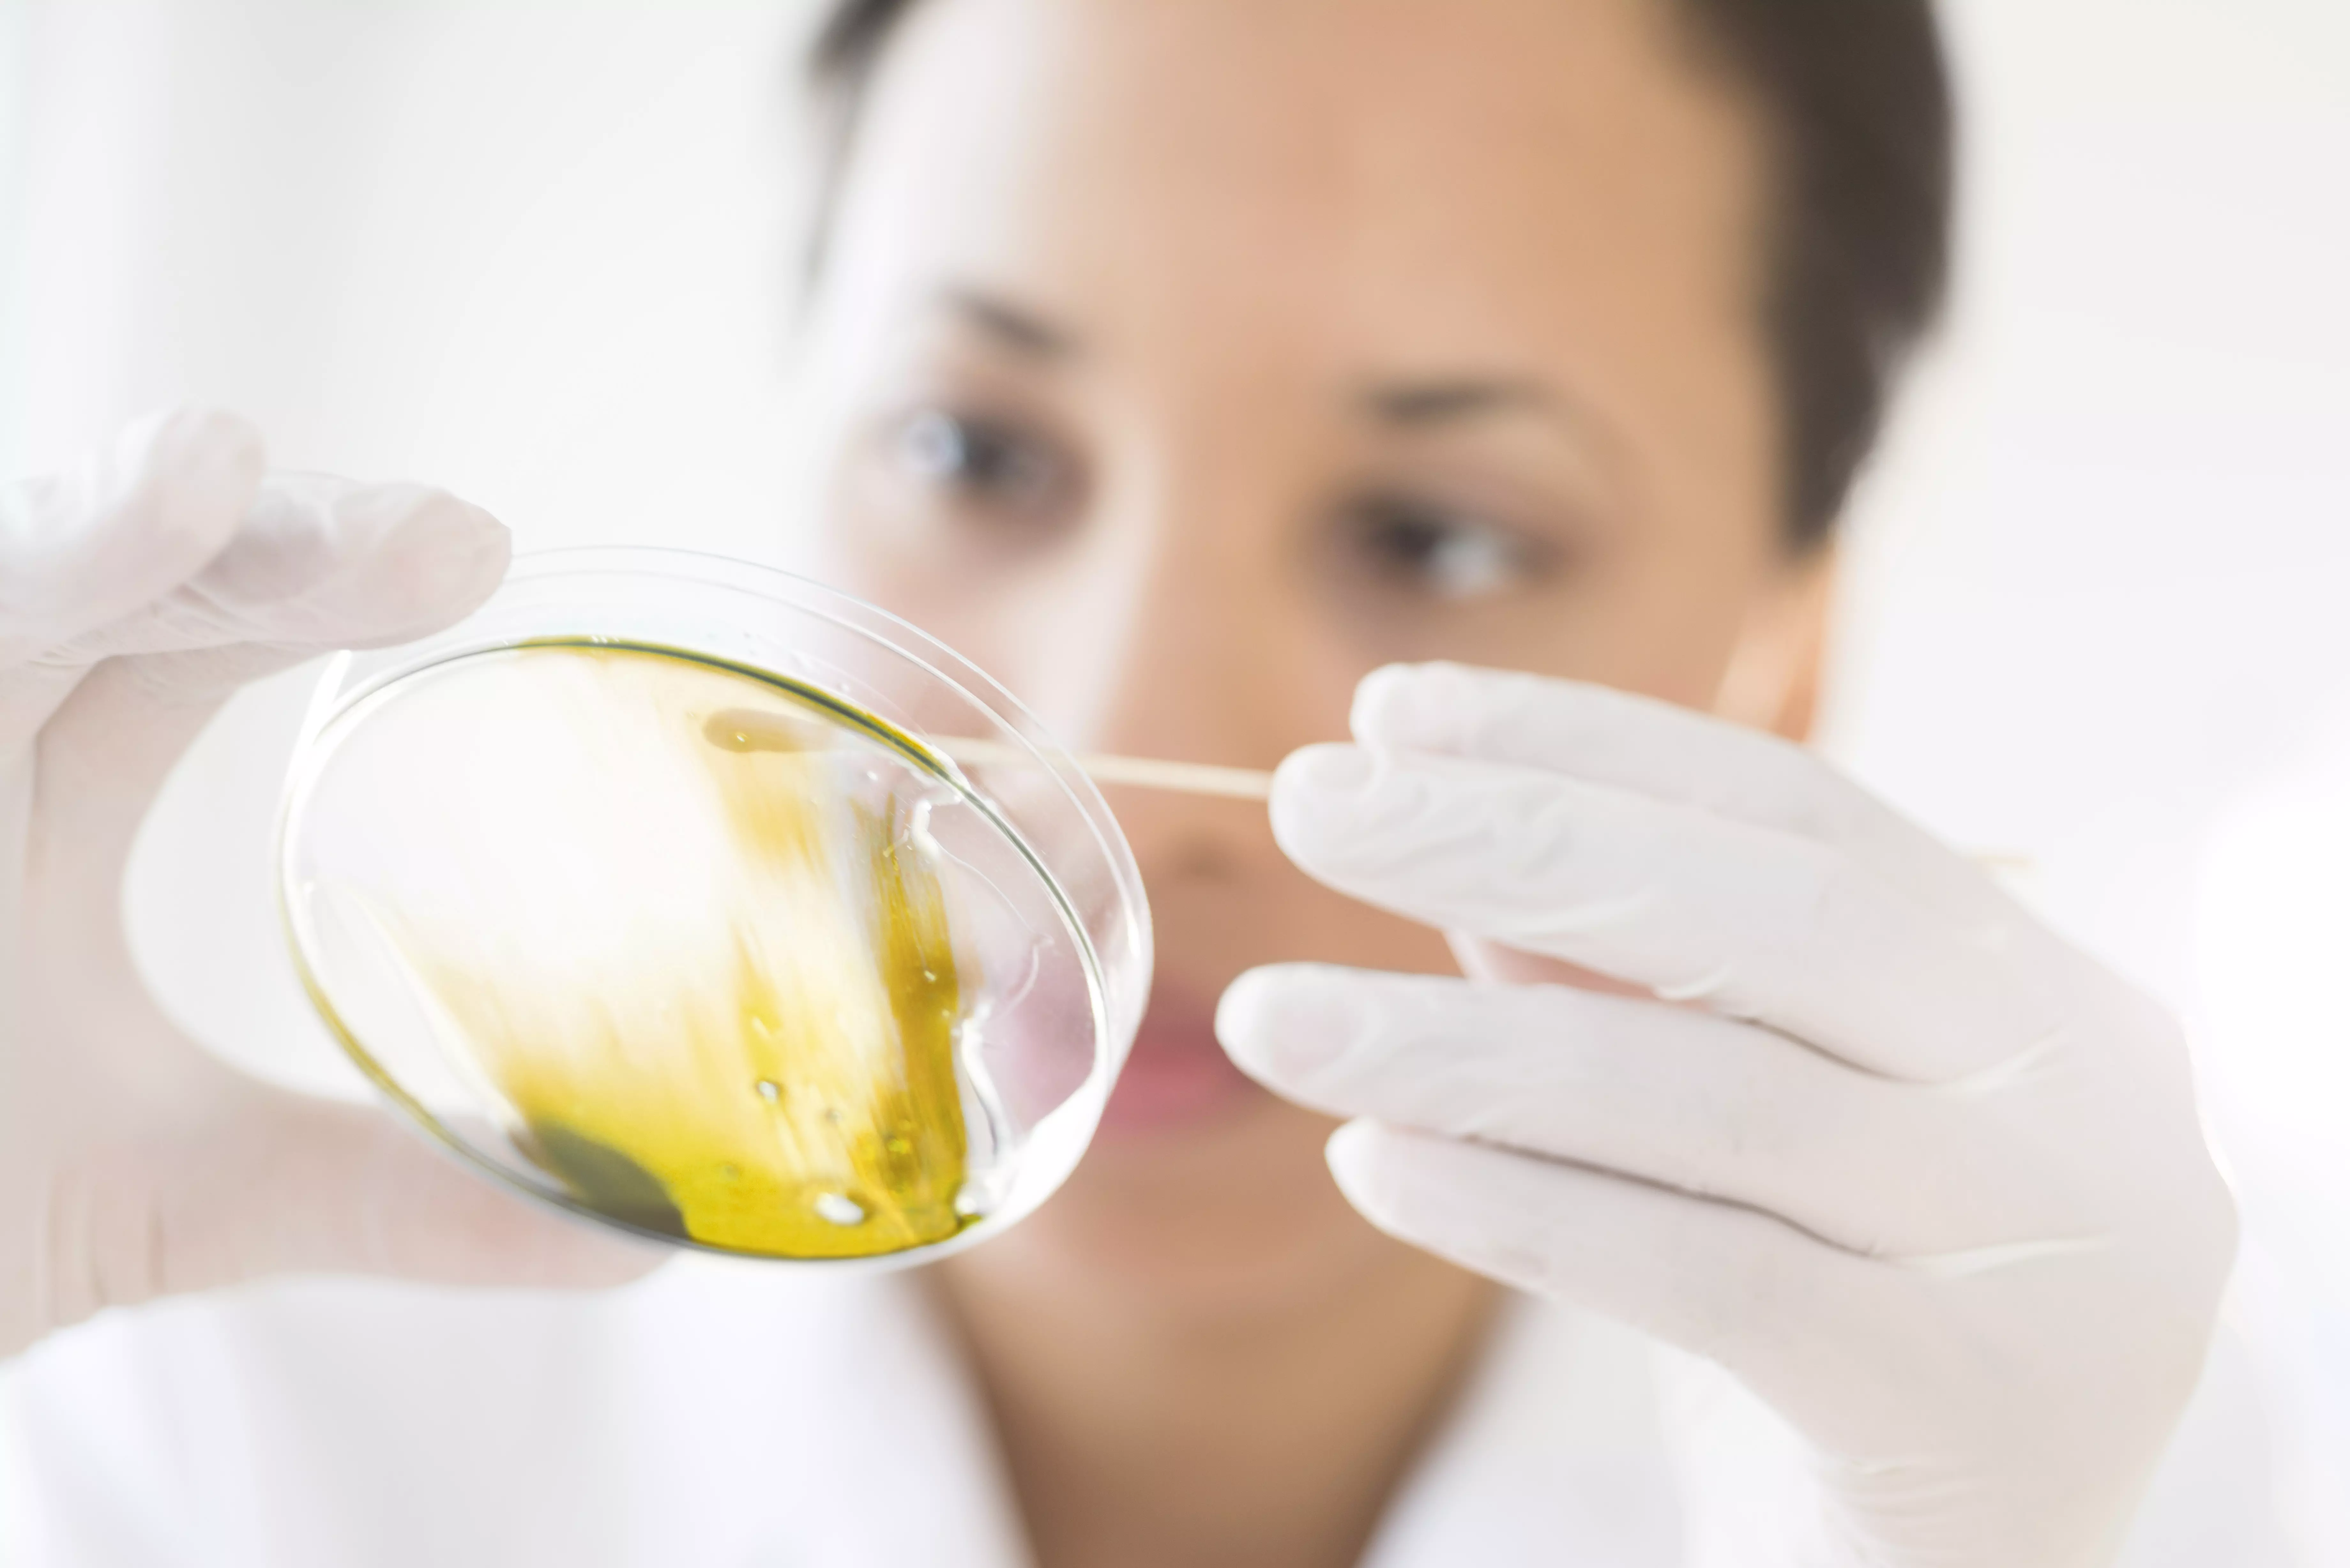
Norevo_Low_Bac_Honey

Unser Produkt
Low-Bac Honig (keimreduziert)
Unser Low-Bac Honig (Low Bacteria = keimreduziert) wurde speziell für mikrobiologisch anspruchsvolle und sensible Produkte entwickelt. Bei dem von uns eigens entwickelten thermischen Verfahren wird der Honig durch Erhitzung keimreduziert.
Produktionsverfahren
Durch diesen sensibel abgestimmten Erhitzungsprozess erfolgt eine effektive Reduktion (4D) der Sporen von Clostridium botulinum, was den Einsatz von Low-Bac Honig auch in Babynahrung ermöglicht.
Die mikrobiologischen Werte jeder Charge werden von unserem Labor nach der Bearbeitung überprüft.

Einsatz
Low-Bac Honig wird beispielsweise in Babynahrung eingesetzt sowie in der Kosmetik- und Pharma-Industrie. Auch für Getränke wird er gerne genutzt.
Qualitäten

Individuelle Qualitäten
Unser Low-Bac Honig ist in verschiedenen standardisierten Qualitäten verfügbar. Es sind aber auch individuelle, auf Ihre Bedürfnisse zugeschnittene Qualitäten möglich.
Anwendungen

Zertifikate
Unser Low-Bac Honig ist Halal und Kosher zertifiziert, aber auch Bio-Qualität und Fairtrade Zertifizierungen sind möglich.
Wir beraten Sie gern persönlich.

Download Broschüre Honig und Bienenprodukte
Hier finden Sie unsere Broschüre mit allen wichtigen Informationen rund um Honig und Bienenprodukte zum Herunterladen.